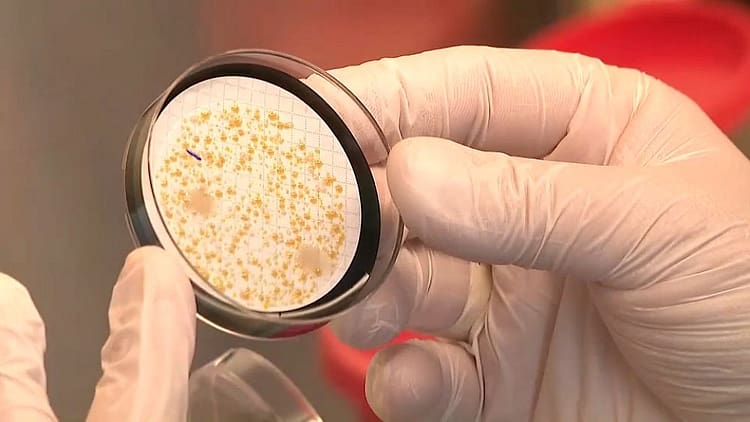
featured

Polonya’nın elindeki Rzeszow’da Legionella bakterisi ile enfeksiyon kaptı ve üç kişinin daha hayatını kaybetti. Bu da hacimli genel toplam 14’e çıkıyor.
REKLAMCILIKDört ilde Legionella pnömofila vakaları tespit edildi ve şu anda 159 kişi enfeksiyon kaptı. Salı günü dokuz yeni vaka bildirildi.
Dört ilde Legionella pneumophila vakaları tespit edildi: Podkarpackie, Lubelskie, Małopolskie ve Wielkopolskie.
Artan sayıdaki lejyonellozis vakalarına yanıt olarak Sağlık Baş Müfettişi Krzysztof Saczka tüm ülke için tavsiyelerde bulundu. Bunlar arasında duşların dezenfekte edilmesi, süzgeçlerin sökülmesi ve yalnızca kaynamış su kullanılması yer almaktadır.
Bağışıklık sistemi zayıf olan yaşlı ve yayılan kişiler Legionella’ya özellikle duyarlıdır. Ancak Legionella pneumophila enfeksiyonu hızlı ve kolay bir şekilde tespit edilebilir.
Lejyonelloz solunum yolu hastalığıdır. Ancak bulaşıcıdır. Suda bulunan ve 20 ila 50 santigrat derece arasında büyüyebilen Legionella bakterilerinden oluşur.